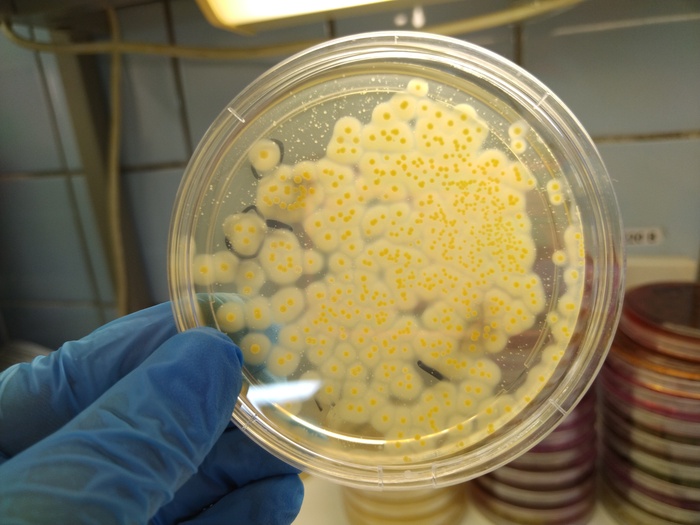

Прошу помощи-совета. 24 марта умер папа. Узнали, что остались кредиты. Какие смогли закрыли сразу. Остался один, в "УБРиР". Получив свидетельство о смерти обратились в банк, 30.03, с заявлением о смерти заемщика и просьбой перестать начислять проценты. Заявление было рассмотренно банк ответил: информацию по счетам предоставить не могут т к это банковская тайна.
Как бы и ладно, вступим в наследство узнаем тайну. А сегодня у нотариуса узнали, что банк продолжает начислять проценты и долг вырос на 15тыс. На горячей линии говорят: идите в отделение, мы вам сказать ничего не можем; в отделении сказали: это головной офис решает останавливать проценты или нет.
Помогите советом, куда обратиться, чтоб остановить это.